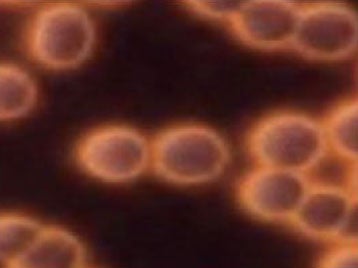

美容大国イスラエル発の最新美容機器「wishpro® 」とは?
「オイルで肌を育てる」という新しいコンセプトで様々な肌質に対応します。
磁気を応用した最先端導入技術であり、赤血球を活性化できる磁場効果を得られます
13種類のスマートスポンジ天然オイルカプセル
4つのハイテクヘッドによって導かれた革新的な素肌管理システム

【wishpro®の特許】
-
磁気注入テクノロジー
MITは正式名マグネティック・インフュージョン・テクノロジーと呼び、磁気の力を応用した磁気注入テクノロジーです。
「ハンドル」+「テクノロジーヘッド」+「美容カプセル」
それぞれの3つの機能がひとつになることで、革新的な磁気を使った導入技術が誕生。
-
スマートスポンジカプセル
『オイルで肌を育てる』という新しいコンセプトのもと革新的な技術で作られた使い切りカプセル美容液。
栄養と潤いをお肌に届けターンオーバーを促進。本来の力を引き出し健康な肌に導きます。
【wishpro®の有効性】
-
wishpro®の有効性❶―赤血球の調整効果
赤血球の内部には酸素を運ぶヘモグロビンを持ち、体内に酸素を運んでいます。
偏った食生活、運動不足、ストレスなどで、赤血球もコインが重なるような形に変化し、血液がドロドロになります。
その為、酸素が十分に体内に供給できず、代謝が低下することでくすみなどの肌トラブルにつながりやすくなります。
wishpro®を使用することで、酸素がより体内に巡りやすい状態に導きます。

wishpro®使用前
・赤血球がお互いに重なり、コインが連なったような状態になっています。
・本来使われるべき赤血球の表面の面積が大幅に少なくなり、体内に運ばれるべき酸素や栄養素が減少します。
wishpro®使用後
・重なっていた赤血球が離れ、より多くの酸素吸収し、栄養も運びやすくなることで体の隅々まで酸素と栄養がいきわたります。
・また赤血球の流れがスムーズになることで、毒素やニ酸化炭素も効率的に排出されるようになります。
-
wishpro®の有効性❷―15分の即効性
1、ハリ
テクノロジーヘッドが肌の深部にアプローチし、コラーゲンやエラスチンの生成をサポート。
内側からふっくらとしたハリのある肌へ。
2、ツヤ
ピーリングと美容液カプセルが肌のキメを整え、なめらかで輝くようなツヤ肌へ導きます。
3、もっちり
天然オイルが肌をやわらげながら、美容成分の浸透をサポート。弾むようなもっちり肌へ。
4、しっとり
磁気の力で導入された有効成分が、肌の内側から潤いを満たし、しっとりとした仕上がりに。
5、透明感
磁気の力で血流がスムーズになり、健康的で明るい肌印象へ。
【wishpro®の安全性】
厳しい安全基準をクリアし、天然成分を豊富に含む美容液カプセルにより、年齢や肌質を問わず幅広い顧客層に利用されています。海外では有名クリニックや芸能人にも多数愛用され、高い信頼と実績を誇ります。
【wishpro®多数の受賞履歴】

フランス・2014
H. Pierantoni Prize forNew Aesthetics
(イノベーション発明賞)

ベルギー・2017
Best Machine Award Pro Esthetic
(最優秀プロエステ機器賞)

香港・2018
PerfectSkin Solution Award
(香港美容大賞)

Beauty Competition Inspiracje Roku 2019
(最優秀革新美容機器賞)

【wishpro®の日本総輸入販売元】
社名:IONiagaJapan株式会社
所在地:〒104-0061 東京都中央区銀座4-14-8 VORT銀座イーストⅢ 9階
営業時間:月曜〜金曜 9:00〜18:00
ウィッシュプロ®を導入検討の方はこちら:https://wishproasia.com/jp/inquiry-jp/
ホームページはこちら:https://wishproasia.com/jp/
Instagram:@wishprojapan
導入のご相談方法:HP内のお問い合わせより
ブランド紹介:
磁気を応用した最先端導入技術であり、赤血球を活性化できる磁場効果を得られます
13種類のスマートスポンジ天然オイルカプセル
4つのハイテクヘッドによって導かれた革新的な素肌管理システム
すべての画像
